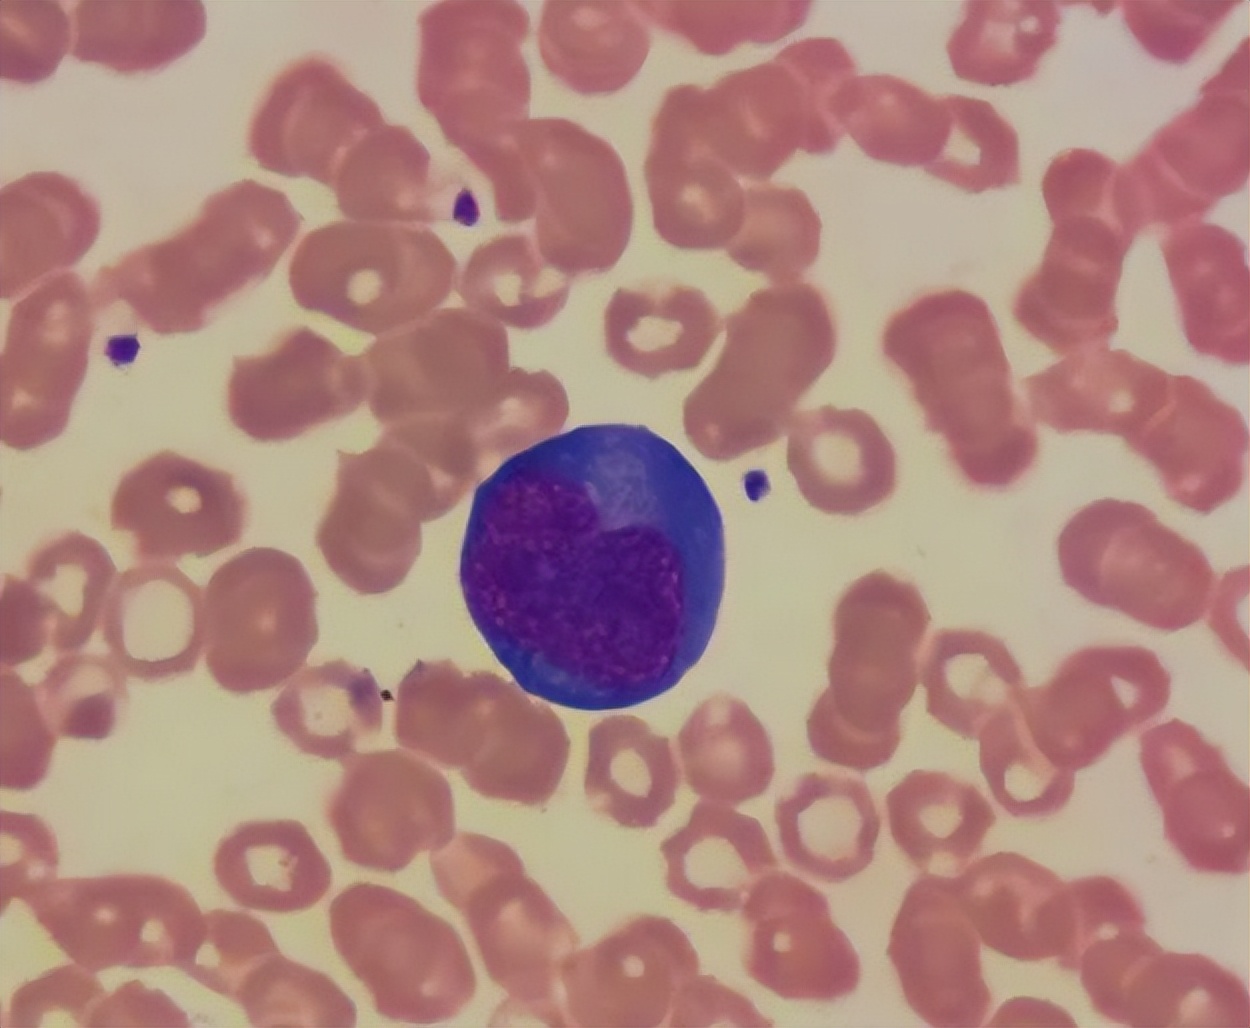
血常规指标高或低多少会有危险,血常规检查3项高有什么病

现在医疗水平都已经比较发达了,越来越多的人开始相信现代医学,当身体出现异常时都会去医院做检查。
医生在诊断之前都会让患者去做血常规检查,血常规检查的项目包括淋巴细胞,红细胞白细胞,血红蛋白,血小板,红细胞等等,一般分为三个系统,分别是白细胞系统,红细胞系统和血小板系统。
最常规检查是体检项目中最基本的一个检查项目,很多人比较疑惑,为什么一去医院做检查就要抽血呢?今天就给大家解答疑惑。

为什么一到医院看病,总是要抽血化验?
抽血化验是医院很多检查的第1步,在做血常规检查的时候,就需要抽血化验,肝功能检查和血糖检查以及肿瘤标志物检查都需要抽血。
很多疾病需要通过抽血化验才能够确诊,有人觉得自己只是感冒了,让医生开个药方回家吃就可以了,医生为了更准确地掌握病情,会建议患者做一个血常规检查。
做血常规检查可以知道到底是什么原因引起的咳嗽和发烧,到底是流感还是普通风寒,到底是季节性的流感还是特殊的病毒流感,这些都能在血常规检查中看出来。

所以说去医院看病的时候,做血常规检查是基础的,也是常见的方法,可以在较小的腹带下,检查出患者体内的问题。如果检查时发现下面这三个指标升高,那么就要引起重视了,需要进一步做检查。
血常规检查中,若这3个指标升高,建议做进一步检查,别不听劝
淋巴细胞数量升高
如果发现淋巴细胞出现了异常,可能是生理性的,也可能是病理性的淋巴细胞占据人体血液总成分的35.9%,依靠内源性分泌和外源性补充得以分合。
如果体内有炎症,那么淋巴细胞数量就会升高,可以通过服用消炎药来控制病情,如果淋巴细胞的数量低于正常范围,也要提高警惕,需要进一步做检查,排除患有白血病或者细胞癌变的风险。
血红蛋白指数升高
血红蛋白的功能是运输血液,将血液中多余的低脂蛋白毒素通过血液循环排出体外,还能够维持人体的血液供应,预防贫血和慢性代谢炎症。
在做血常规检查时,如果发现血红蛋白指数升高,可能是脑细胞过于紧张造成的,同时也要警惕脑梗或者是血栓,需要进一步做检查。
白细胞数量升高
在做血常规检查时,如果发现白细胞数量升高,可能是出现了感染,也可能是体内有炎症,此时要看身上有无临床症状。

如果出现了临床症状,就要及时治疗,白细胞升高还可能跟血液系统疾病有关系,比如骨髓增生和白血病。
病毒性的感染和细菌性的感染也会导致白细胞数量升高,病毒性感染会引起淋巴细胞数量升高,细菌性感染会造成中性粒细胞升高,所以需要进一步做检查。
为什么有时候抽血,需要抽好几管?
我们在抽血的时候有时候需要抽好几管,这是为什么呢?其实每个患者的检查项目都是不一样的,不同的检查项目对于血压成分的要求也是不同的。

如果只抽一管血的话,不能满足所有检查项目的需求,就算用一管血化验在不同的化验室进行化验,也可能出现污染的现象,对于诊断结果会造成影响。
所以说抽好几管血是为了方便,如果一次性抽一管血,为了满足检查项目需求,护士会再次用针管将抽取的血液放入不同的容器当中。
在这个过程当中有可能出现污染的现象,所以抽好几管能够节约时间,也能够节约人力,大家不用担心,出血过多不会导致不必要的情况发生。
举报/反馈